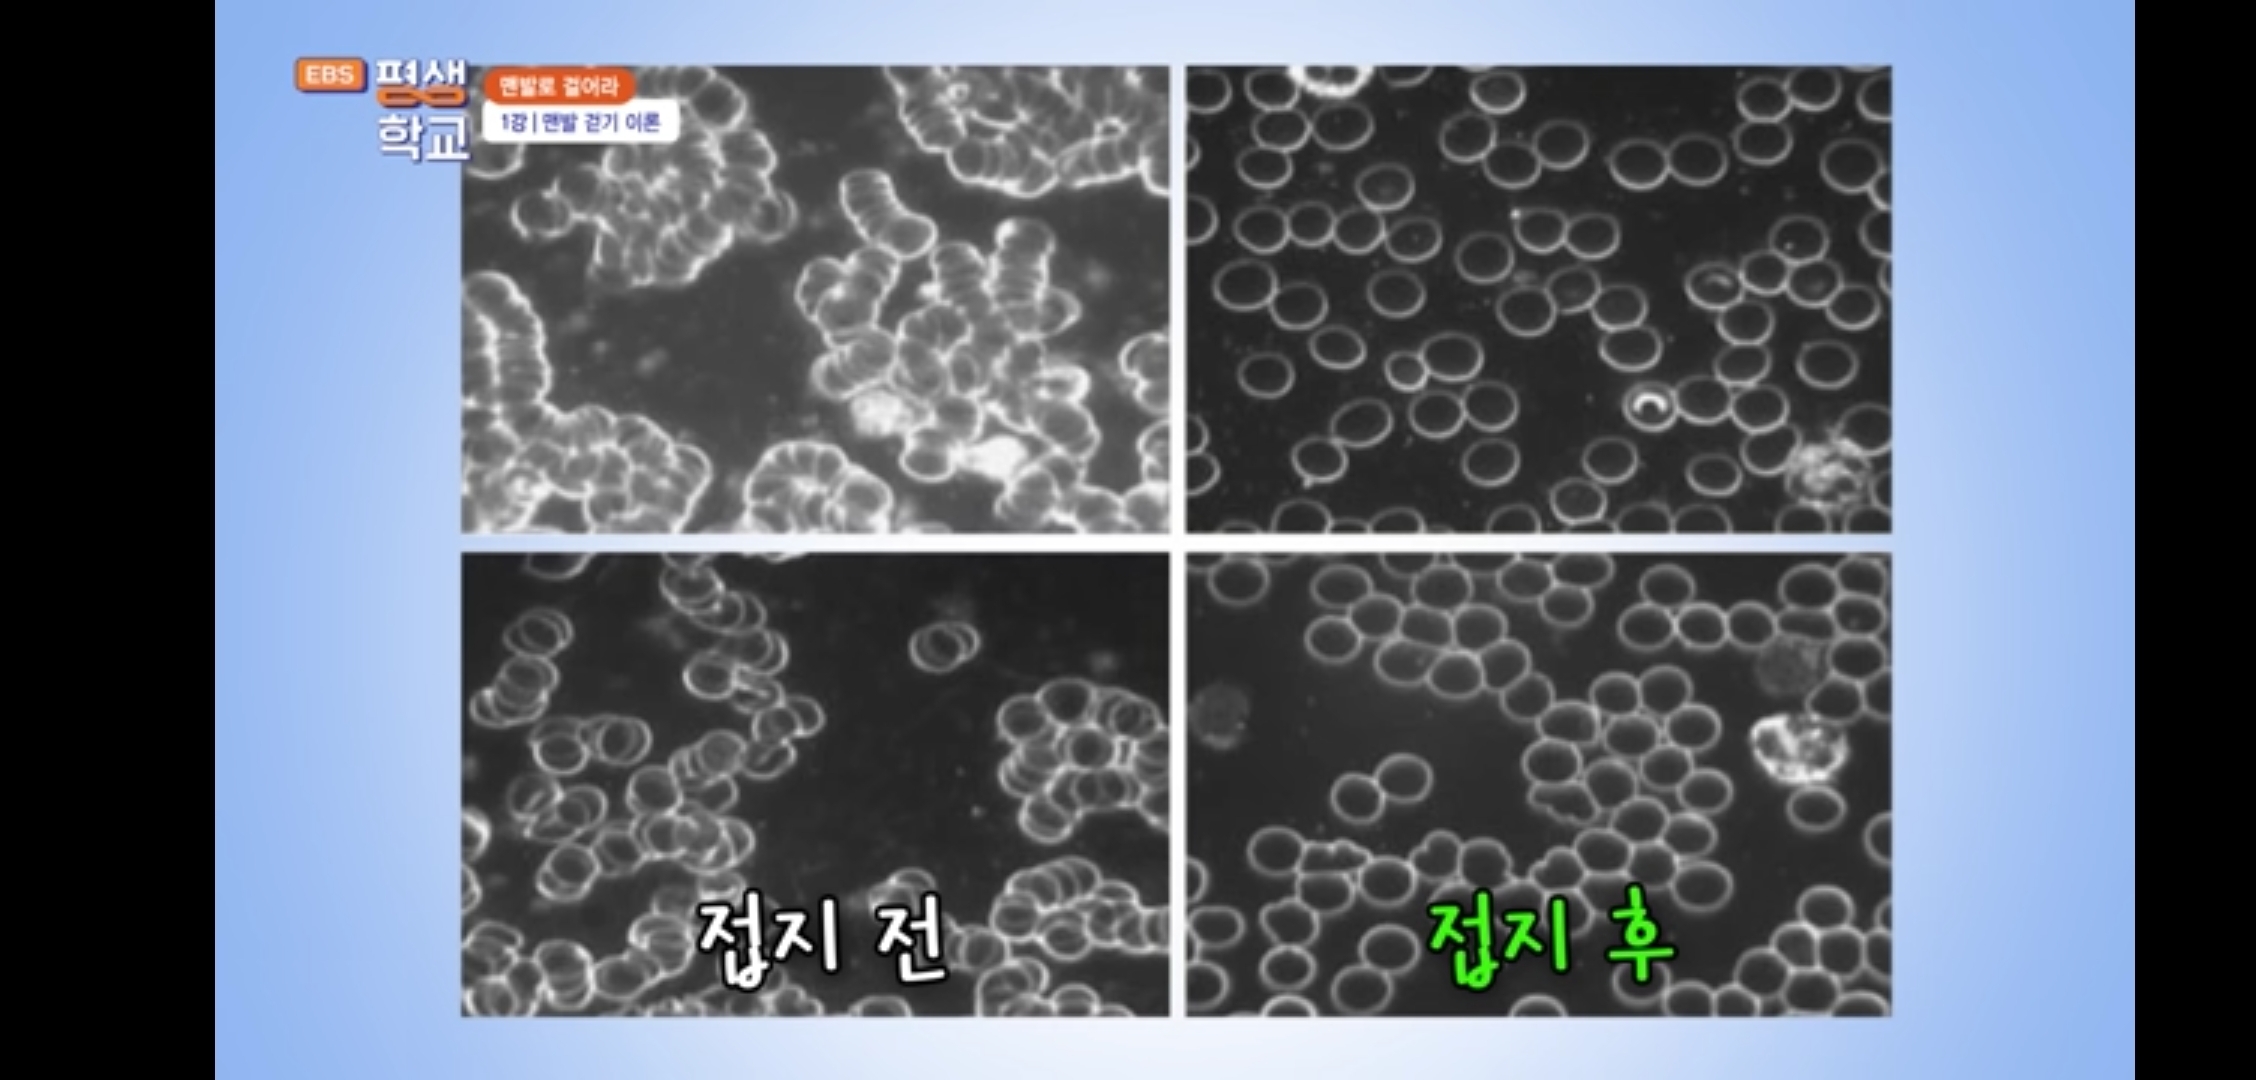

맨발 걷기[접지(Earthing)+지압]의 기적]
●[책 소개 영상]
두달 안에 아픈 곳이 나아지는
<맨발 걷기의 기적>(저자 박동창)
*맨발 걷기의 힘:
1) 조물주의 설계도에 따른 삶의 방식
2) 3무(무입원,무병상,무진료비) 자연치유 종합병원으로
종합 자연치유력을 높인다
3) 걷기만으로 이룰 수 없는 '+알파의 치유력'을 더한다
=접지(Earthing) 효과
[케이독서대학, 2022.6.4(19분)]
《꼭 보세요!》
●[책 소개(책읽음) 영상]
맨발로 걸으라!
-접지 및 지압 효과로 건강해진다!
(박동창 지음)
[책한민국, 22.10.4(55분)]

~~~~~
●[박동창의 맨발로 걸어라]
<맨발 걷기 운동 1강>
맨발 걷기 이론
1. 지압 이론
2. 접지 이론
3. 발바닥 아치와 발가락 이론
[EBS평생학교, 2023.6.28(13분)]

~~~~~
●[박동창의 맨발로 걸어라]
<2강> 접지
1. 접지 효과 실험-음식,식물,동물 등
2. 맨발 걷기 방법
-하루 세끼 식사하듯 하루 3회 하는 게 좋다
-최소 약30분~1시간, 많이 걸을수록 좋다(다다익선)
-접지와 지압 효과를 극대화 할 수 있는 7가지 걸음:
1)두꺼비 걸음-땅과 일체가 되는 걸음
2)황새 걸음-뒤꿈치부터 발끝까지 둥글게 걷기
3)까치발 걸음-발끝에 지압효과, 머리를 건강하게 함
4)잇몸 우물 걸음-발가락 만세부르기, 발 허리에 지압효과
5)주걱 엎은 걸음-발가락 끝쪽 지압효과 극대화, 머리 끝쪽 지압효과 극대화
6)스탬프 찍듯 걸음-발가락을 부채살처럼 펴고 끌어당기기
7)뒤로 걷는 걸음-시선은 45도 전방,
두 사람이 한분은 앞을 보고, 한분은 뒤를 보고 손잡고 걸으면
뒤의 위험물을 피할 수 있다.
-겨울에는 두꺼운 양말 바닥에 구멍 내기
[EBS평생학교, 23.6.29(13분)]
~~~~~~~~~~~~~
●건강이 걱정되신다면
제발 제 얘기를 들어주세요!
저도 효과를 봤습니다!
-맨발로 걷기만 했을 뿐인데 모든 병이 치유된다?
-맨발걷기(접지,지압)의 치유 원리
-맨발걷기 방법, 주의할 점
<박동창(맨발걷기국민운동본부 회장)>
[셀코TV, 23.10.30(25분)]
https://youtu.be/Z5YvCYOEfd0?si=jYx09Db_NZ-xXsTw
~~~~~~~~~~~~~~~
●맨발로 걷는 사람과 걷지 않는 사람의 차이는
생과 사를 가르는 결정적 원인이 된다!
(링크 보세요)
https://m.cafe.daum.net/saintfullgospel/LnEd/564
●[흙길 맨발걷기]
cf. 토종닭 vs 양계닭
(링크 보세요)
https://m.cafe.daum.net/saintfullgospel/LnEd/566
~~~~~
●"맨발걷기 10분만에 피 맑아진 환자
...해외 의사도 증언한 땅의 치유력"
맨발로 걸으라!
[중앙일보, 2022.4.8]
●"병의 90%는 걷기만 해도 낫는다"
-나가오 가즈히로 지음
[책 소개 영상(22분)]
~~~
●우울증 약 먹기 전에
꼭 해볼 '맨발걷기'의 과학적 효과 총정리
[라라의 힐링공감, 22.10.27(6분)]
●맨발걷기의 기적,
주인공 인터뷰/
신장투석 위기에서 맨발걷기 1년만에 정상으로/
수원 만석공원
[모든날의기적, 2022.1.19(18분)]
●접지(Earthing) 후 혈액 현미경.
적혈구는 이 "접지" 후에 더 잘 순환합니다.
[영상(1분 14초)]
https://band.us/band/79549191/post/7179
~~~
●발이 땅에 닿는 순간 이렇게 됩니다.
-맨발걷기(접지)의 효과
[영상(50초)]
https://band.us/band/79549191/post/9220

~~~~~
●맨발 접지:
대지와 동기화
[영상(59초)]
https://band.us/band/79549191/post/9103
●맨발 접지와 힐링⚡️
[영상(59초)]
https://band.us/band/79549191/post/8791
~~~~~
●접지(Earthing)
-최적 건강상태를 위한 지구 에너지 사용법
[Live Young/Darnell Cox, 2022.4.10(3분27초)]

~~~
=========================
■ 맨발걷기 기본 가이드-맨발걷기 효과, 치유의 원리, 맨발걷기 방법, 맨발걷기 시 주의점 등(링크 보세요)https://m.cafe.daum.net/saintfullgospel/LnEd/562
~~~
●[초보를 위한 어씽(Earthing:접지) 총정리]
어씽하는 방법부터 효과를 높이는 팁까지!
[라라의 힐링공감, 2022.11.3(8분)]
~~~~~~~~~~~
♤만병의 원인인 활성산소를 없애주는 방법
-흙길 맨발걷기(Earthing:접지), 항산화물질, 소금, 수소수
●[소금과 수소이온은 활성산소 킬러]
1. 만병의 원인인 활성산소(호흡찌꺼기,양전하) 중화(제거) 방법:
1) 어싱(Earthing:접지)=흙길 맨발걷기
-양전하인 활성산소를 음전하인 땅으로 중화,소멸시킴
2) 항산화 물질(유기농 과일,채소 등) 섭취
3) 강력한 항산화 물질인 수소수(수소이온) 섭취
2. 소금은 활성산소를 막아주고 산성화된 혈액을 알칼리로 환원시켜 줌(정혈작용)
[맨발걷기국민운동본부, 김도남, 22.8.18]
~~~~~~~
●맨발걷기(Earthing:접지) 1년만에 나타난 14가지 효과:
1. 수면질 개선: 깊은 잠, 개운한 잠
2. 혈압 정상화: 혈압약을 끊었다
3. 신체 피로도 개선: 눈이 맑아 업무집중도 향상
4. 알레르기 비염 개선: 봄,가을 증상 나타나지 않음
5. 당뇨증상 개선: 공복혈당, 당화혈색소 정상화
6. 역류성식도염 개선: 증상 안 나타남
7. 과민성대장증후군 개선: 배변활동 정상화
8. 전립선비대증 개선: 소변 정상화
9. 탈모증상 개선: 탈모현상 벗어남
10. 족저근막염 완치: 20년만에 흔적없이 사라짐
11. 암세포 섬멸하는 NK세포 4배 활성화
12. 지방간,중성지방 수치 개선: 내장지방 함께 개선
13. 내장비만 해소: 체중(내장지방) 5kg 빠져 온 몸 정상화
14. 정서적 안정 회복: 우울감,정서불안,두려움 개선
[장태동행정사TV, 24.5.13(19분)]
https://youtu.be/ZcDZv1TD__s?si=pFf26nMURzXCWObF
●맨발걷기국민운동본부 7주년 기념 특집 영상
[박동창의 맨발강의, 23.7.26(15분)]
~맨발걷기 종합 내용 담김.
●"몸 아프면 병원 가는 익숙함 버리고,
맨발걷기로 건강 새 지평 열기를"
-신발 착용의 고정관념 벗어나야
<박동창의 맨발걷기학(6)>
[파이낸셜뉴스, 24.4.5]
~~~
《꼭 시청! 전달!》
●[맨발걷기 완결판(통합본)]
-맨발걷기 전에 반드시 봐야 할 영상
-이렇게 해야 효과 높아집니다!
-가장 많이 물어보는 맨발걷기에 관한 중요한 질문들을 속시원하게 풀어드립니다
[박동창 회장 통합본(59분)]
https://youtu.be/VSIswdGJJH4?si=j1t_niH12LtuQh30
~~~
==============================
■ [필독!}
우리 인생에서 가장 중요한 것은?
(링크 보세요)
https://m.cafe.daum.net/saintfullgospel/H2Yt/153
~~~~~~~~